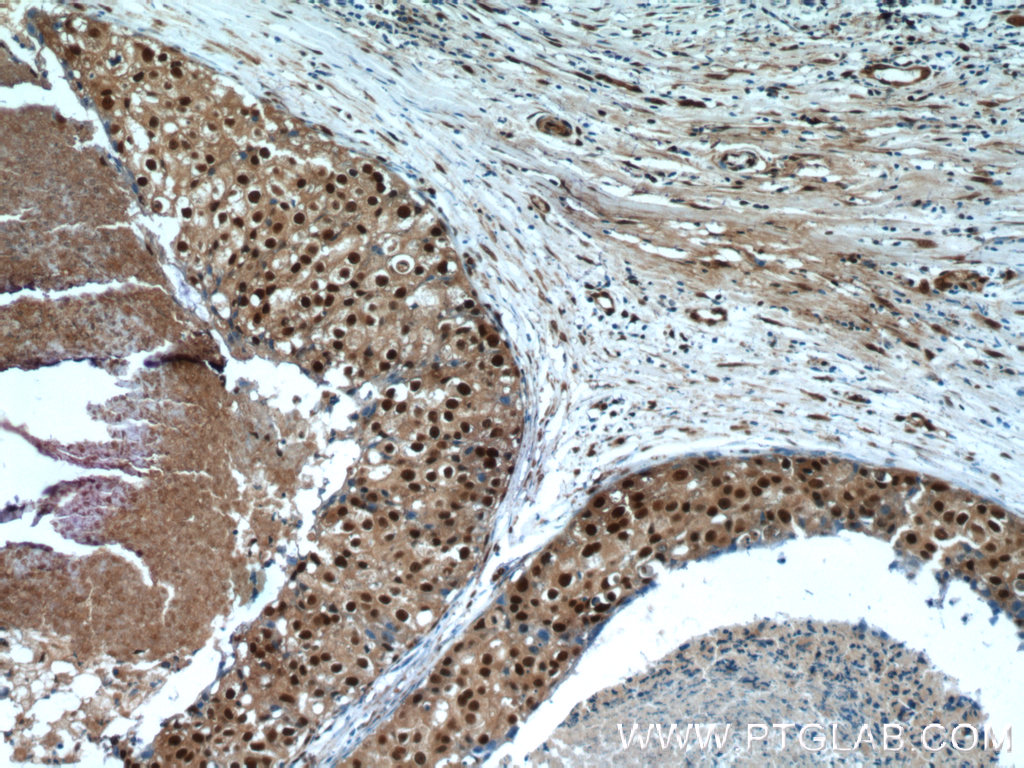

验证数据展示
经过测试的应用
| Positive WB detected in | A2780 cells, HEK-293 cells |
| Positive IHC detected in | human breast cancer tissue, mouse testis tissue Note: suggested antigen retrieval with TE buffer pH 9.0; (*) Alternatively, antigen retrieval may be performed with citrate buffer pH 6.0 |
| Positive IF/ICC detected in | MCF-7 cells |
| Positive FC (Intra) detected in | MCF-7 cells |
推荐稀释比
| 应用 | 推荐稀释比 |
|---|---|
| Western Blot (WB) | WB : 1:2000-1:10000 |
| Immunohistochemistry (IHC) | IHC : 1:20-1:200 |
| Immunofluorescence (IF)/ICC | IF/ICC : 1:200-1:800 |
| Flow Cytometry (FC) (INTRA) | FC (INTRA) : 0.80 ug per 10^6 cells in a 100 µl suspension |
| It is recommended that this reagent should be titrated in each testing system to obtain optimal results. | |
| Sample-dependent, Check data in validation data gallery. | |
发表文章中的应用
| WB | See 8 publications below |
| IHC | See 1 publications below |
产品信息
24655-1-AP targets SRA1 in WB, IHC, IF/ICC, ELISA applications and shows reactivity with human, mouse samples.
| 经测试应用 | WB, IHC, IF/ICC, ELISA Application Description |
| 文献引用应用 | WB, IHC |
| 经测试反应性 | human, mouse |
| 文献引用反应性 | human, mouse |
| 免疫原 | SRA1 fusion protein Ag20082 种属同源性预测 |
| 宿主/亚型 | Rabbit / IgG |
| 抗体类别 | Polyclonal |
| 产品类型 | Antibody |
| 全称 | steroid receptor RNA activator 1 |
| 别名 | Steroid receptor RNA activator protein, Steroid receptor RNA activator 1, SRAP, PP7684 |
| 计算分子量 | 26 kDa |
| 观测分子量 | 30 kDa, 33 kDa |
| GenBank蛋白编号 | BC067895 |
| 基因名称 | SRA1 |
| Gene ID (NCBI) | 10011 |
| RRID | AB_2879657 |
| 偶联类型 | Unconjugated |
| 形式 | Liquid |
| 纯化方式 | Antigen affinity purification |
| UNIPROT ID | Q9HD15 |
| 储存缓冲液 | PBS with 0.02% sodium azide and 50% glycerol , pH 7.3 |
| 储存条件 | Store at -20°C. Stable for one year after shipment. Aliquoting is unnecessary for -20oC storage. |
背景介绍
Steroid receptor RNA activator 1 (SRA1), also known as seroid receptor RNA activator protein (SRAP) or SRA, is involved in modulating the activity of multiple transcription factors including the estrogen receptor (ER) (PMID: 20398657). It may play a role in tumorigenesis (PMID: 16152589). The SRA1 gene encodes both SRA1 protein and a non-coding functional RNA that functions as part of a ribonucleoprotein complex activating steroid receptor induced transcription. This polyclonal antibody recognizes endogenous SRA1 isoforms which migrate as a doublet on SDS-PAGE gels (PMID: 12565891; 23907597).
实验方案
| Product Specific Protocols | |
|---|---|
| WB protocol for SRA1 antibody 24655-1-AP | Download protocol |
| IHC protocol for SRA1 antibody 24655-1-AP | Download protocol |
| IF protocol for SRA1 antibody 24655-1-AP | Download protocol |
| Standard Protocols | |
|---|---|
| Click here to view our Standard Protocols |
发表文章
| Species | Application | Title |
|---|---|---|
Free Radic Biol Med Up-regulation of thioredoxin system by puerarin inhibits lipid uptake in macrophages | ||
Phytomedicine Rice bran active peptide (RBAP) inhibited macrophage differentiation to foam cell and atherosclerosis in mice via regulating cholesterol efflux | ||
Arterioscler Thromb Vasc Biol RP5-833A20.1/miR-382-5p/NFIA-Dependent Signal Transduction Pathway Contributes to the Regulation of Cholesterol Homeostasis and Inflammatory Reaction. | ||
J Lipid Res A lincRNA-DYNLRB2-2/GPR119/GLP-1R/ABCA1-dependent Signal Transduction Pathway Is Essential for the Regulation of Cholesterol Homeostasis and Inflammatory Reactions. | ||
J Lipid Res VNN1 Promotes Atherosclerosis Progression in apoE Deficiency Mice Fed a High Fat High Cholesterol Diet. | ||
PLoS One Dihydrocapsaicin Attenuates Plaque Formation through a PPARγ/LXRα Pathway in apoE(-/-) Mice Fed a High-Fat/High-Cholesterol Diet. |